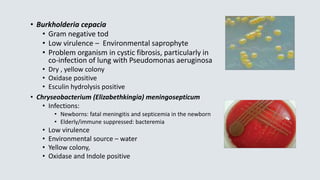
• Burkholderia cepacia
• Gram negative tod
• Low virulence – Environmental saprophyte
• Problem organism in cystic fibrosis, particularly in
co-infection of lung with Pseudomonas aeruginosa
• Dry , yellow colony
• Oxidase positive
• Esculin hydrolysis positive
• Chryseobacterium (Elizabethkingia) meningosepticum
• Infections:
• Newborns: fatal meningitis and septicemia in the newborn
• Elderly/immune suppressed: bacteremia
• Low virulence
• Environmental source – water
• Yellow colony,
• Oxidase and Indole positive

This document provides definitions and information about common aerobic bacteria:
- It defines different types of bacteria based on their oxygen requirements including obligate aerobes and anaerobes.
- It describes appropriate specimen collection and transport methods for different specimen types.
- Key identification tests for common gram positive cocci like Staphylococcus, Streptococcus, and Enterococcus are summarized.
- Antibiotic resistance in Staphylococcus aureus including MRSA is discussed.
- Identification of clinically relevant beta hemolytic streptococci is covered.





















![Streptococcus pyogenes
• Group A Streptococcus [GAS] – very beta hemolytic on blood agar
• Biochemical tests used for identification:
• Bacitracin KB sensitivity test – GAS are inhibited by antibiotic
Bacitracin
• This test is not specific for GAS, inhibition also occurs with
Beta hemolytic Streptococcus group C
• PYR (pyrrolidonyl arylmidase) reaction
• Organism spotted onto moist PYR disk
• 2 min – RT incubation
• Add Cinnamaldehyde reagent
• Pink = positive = Streptococcus pyogenes
• This test is not exclusive for Strep pyogenes –
Enterococcus and Staph lugdunensis also pink (+)
• Therapy : Penicillin, Amoxicillin or Cephalosporin
antibiotics
No resistance reported to these agents
PYR](https://image.slidesharecdn.com/webbacteriology20201-200330001843/85/Bacteriology-Update-2020-22-320.jpg)




![Strep agalactiae [GBS]
• Pathogen of the elderly – Causes bacteremia and urinary tract infection, acquisition most likely
from the intestine
• Pathogen of neonate bacteremia or CNS – In utero or perinatal organism acquisition during
birthing process, infection in @ 1/2000 births
• Early onset infection – within 7 days of birth
• Late onset infection - within 8 – 28 days of birth
• Treatment: Penicillin or Cephalosporin (3rd generation)
• @ 25% of pregnant women colonized in the cervix and/or rectal area with GBS
• All pregnant must be screened at 35 – 37 weeks of pregnancy for GBS (Regulation)
• Enrichment methods for GBS screening are standard of practice
• Cervix and Rectal swab incubated in an enrichment broth for 18 hours at 35 ˚C then
cultured onto Blood agar. Enrichment broth can also be used to increase sensitivity in
molecular testing methods
• Ampicillin drug of choice to treat GBS positive pregnant woman during delivery
• Susceptibility testing for alternative therapies must be performed in PCN allergy
• Clindamycin testing with Inducible resistance testing confirmation must be done prior to
using Clindamycin](https://image.slidesharecdn.com/webbacteriology20201-200330001843/85/Bacteriology-Update-2020-27-320.jpg)













![Neisseria gonorrhoeae
• STD – sites of infection include urethrae, endocervix, ocular, rectal,
oropharynx, septic arthritis
• 10-20 % female ascend to PID but only 0.5% disseminate throughout body
• Gram stain of urethral discharge useful for male diagnosis only
• Gram stain of cervix can be problematic due to NF look alike organisms,
such as Acinetobacter species in the female
• Transport for culture – charcoal swabs at room temperature
• Media: Selective Thayer Martin or Martin Lewis agar, chocolate type agar
with increased nutrition and antibiotic trimethoprim
• Amplification methods [PCR] have become standard of practice, improved
sensitivity comparted to culture methods
• Has both beta lactamase enzyme and Chromosomal resistance
mechanisms
• Therapy: Ceftriaxone + Azithromycin or Doxycycline, combination therapy
to prevent development of resistance](https://image.slidesharecdn.com/webbacteriology20201-200330001843/85/Bacteriology-Update-2020-41-320.jpg)












![• Escherichia coli
• Normal flora in human intestine
• #1 cause of UTI [@80% of cases]
• Also, bacteremia, neonatal meningitis,
and abdominal infections
• Ferments lactose when grown on MacConkey agar
• Spot indole reaction = positive / robin’s egg blue color
• Detects breakdown of tryptophan from growth on blood agar
• Green sheen produced when grown on Eosin methylene blue agar (EMB)
• Pathogen of diarrhea:
• Enterotoxigenic (ETEC) E. coli is the cause of traveler’s diarrhea
• Enterohemorrhagic E. coli (EHEC) (such as 0157:H7)
• Bloody diarrhea acquired from eating undercooked meat from an infected
cow – pathogenicity from Shiga toxin production
• Hemolytic uremic syndrome (HUS) can result [hemolytic anemia,
thrombocytopenia, and renal failure] particularly in young children
• When grown on MAC agar with sorbitol / does NOT ferment sorbitol/ most
all E. coli except EHEC ferment sorbitol
Green sheen on
EMB agar
Indole positive
Lactose
fermentor](https://image.slidesharecdn.com/webbacteriology20201-200330001843/85/Bacteriology-Update-2020-54-320.jpg)


![1. Glu/lac/suc
fermented
with gas
2. Glucose
fermented
3. Glucose
fermented
with H2S
4. No CHO
fermentation
Non fermenter
Triple Sugar Iron Agar (TSI)– Used to detect fermentation of glucose,
lactose and/or sucrose and production of hydrogen sulfide [H2S] in GNRs
CHO Fermentation= yellow medium
Gas production= Disruption of the agar
H2S
No CHO
fermentation =
Red medium
1 2 3 4](https://image.slidesharecdn.com/webbacteriology20201-200330001843/85/Bacteriology-Update-2020-57-320.jpg)
![• Salmonella species
• Diarrhea with +/- fever – polys in the stool
• Infection from eating contaminated food (such as raw eggs) or direct
contact with a sick animal
– must ingest large #’s of organisms to make you ill (1,00,000 bacteria),
normal levels of stomach acid is protective
• Does not ferment lactose
• Produces hydrogen sulfide on TSI slant and selective agars
• Motile
• Identification based on biochemical reactions and serologic typing
• Kaufman White serologic typing for speciation of Salmonella
• O Somatic (cell wall) antigen – Salmonella group “B”
• H flagellar antigens – 2 phases [h1 & h2]
• Vi capsular antigen – Salmonella typhi only](https://image.slidesharecdn.com/webbacteriology20201-200330001843/85/Bacteriology-Update-2020-58-320.jpg)

![Shigella
• Diarrhea, +/-vomiting, fluid loss, polys and blood in stool
• Infection : Human to human transmission /control with good hand
hygiene
• Ingestion of low #’s of organisms make you ill [10 – 100 bacteria]
• Does not ferment lactose
• Non motile
• No H2S produced
• 4 species based on somatic antigen
• S. boydii Group C
• S. dysenteriae Group A
• S. flexneri Group B
• S. sonnei Group D](https://image.slidesharecdn.com/webbacteriology20201-200330001843/85/Bacteriology-Update-2020-60-320.jpg)
![Salmonella Shigella Agar (SS agar)
Salmonella and Shigella are colorless
due to lactose not being fermented –
H2S produced by Salmonella turning
colony black
Hektoen agar –
Salmonella produces H2S [Hydrogen sulfide]
producing black colonies
Shigella – green colonies
Normal flora – orange colored due to
fermentation of lactose (E. coli)
Non-Lactose fermenter
Shigella
Salmonella
Normal Flora
Lactose fermented
H2S](https://image.slidesharecdn.com/webbacteriology20201-200330001843/85/Bacteriology-Update-2020-61-320.jpg)

![Haemophilus influenzae
• Transmission – close contact/secretions
• Virulence factor – capsular polysaccharide
• Small pleomorphic Gram negative rod
• Requires 2 nutritional factors for growth:
• X factor = hemin
• V factor = NAD (nicotinamide adenine dinucleotide)
• Grows on chocolate agar (has X and V factor)
• Will not grow on 5% sheep’s blood agar
• Requires C0₂ [5 – 8%] for growth
• Effective vaccine targets invasive infections with H. influenzae type B (HIB)
– effectively eliminating most childhood invasive infections
• Resistance to Ampicillin due to beta lactamase enzyme productions [25 %],
3rd generation Cephalosporin becomes the antibiotic of choice
(Ceftriaxone) for invasive infections](https://image.slidesharecdn.com/webbacteriology20201-200330001843/85/Bacteriology-Update-2020-70-320.jpg)



























![• C. septicum –
• Bacteremia or Gas Gangrene in patient with underlying
malignancy
• Hematogenous spread from GI tract – no trauma necessary
• Clostridioides (Clostridium) difficile –
• Disease: antibiotic associated colitis, pseudomembranous
colitis from toxin production
• Toxin A – enterotoxin causing fluid accumulation
• Toxin B – potent cell cytotoxin – primary virulence
• Binary toxin – so called Nap1 strain is produces larger amount of
toxin
• Diagnosis of infection:
• EIA methods [toxin A/B] are insensitive but detect active toxin
• PCR methods [toxin A/B] are more sensitive, detect toxin genes
• Culture – Cycloserine, Cefoxitin, Fructose Agar [CCFA]
• Infants have @ 70% colonization rate – do not test](https://image.slidesharecdn.com/webbacteriology20201-200330001843/85/Bacteriology-Update-2020-98-320.jpg)


